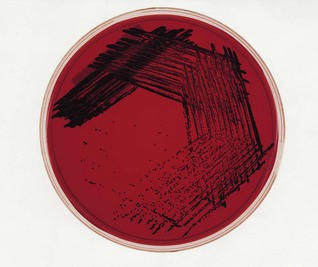
image

Chapter 17 Bacteroides, Tannerella, Porphyromonas and Prevotella
The genera described in this chapter are obligately anaerobic, short Gram-negative rods or coccobacilli. Historically, only the Bacteroides genus was known, but the application of new taxonomic techniques has resulted in the definition of three additional genera: Tannerella, Porphyromonas and Prevotella. Together they comprise a substantial proportion of the microflora of the dental plaque, intestine and the female genital tract (Table 17.1):
Table 17.1 Anaerobic Gram-negative bacilli of clinical interest
| Organism | Main colonization sites |
|---|---|
| Bacteroides | |
| B. fragilis group | Colon |
| B. fragilis | |
| B. ovatus | |
| B. vulgatus | |
| B. distasonis | |
| B. capillosus | Colon, oropharynx |
| B. ureolyticus | Oropharynx, intestine, genitourinary tract |
| Tannerella | |
| T. forsythia | Oropharynx |
| Porphyromonas | |
| P. gingivalis | Oropharynx |
| P. endodontalis | Oropharynx |
| Prevotella | |
| P. intermedia | Oropharynx |
| P. nigrescens | Oropharynx |
| P. melaninogenica | Oropharynx |
| P. loescheii | Oropharynx |
| P. pallens | Vagina, oropharynx |
| P. corporis | Vagina, oropharynx |
Collectively, Tannerella, Porphyromonas and Prevotella species are referred to as black-pigmented anaerobes, as some organisms from these genera form a characteristic brown or black pigment on blood agar (Fig. 17.1).
Fig. 17.1 Black-pigmented colonies of periodontopathogen Porphyromonas gingivalis on blood agar. The pigment is thought to be related to breakdown products of the blood.
Bacteroides
Bacteroides fragilis
Habitat and transmission
Bacteroides species are the most predominant flora in the intestine (1011 cells per gram of faeces), far outnumbering Escherichia coli. They cause serious anaerobic infections such as intra-abdominal sepsis, peritonitis, liver and brain abscesses, and wound infection.
Characteristics
Strictly anaerobic, Gram-negative, non-motile, non-sporing bacilli, but may appear pleomorphic. The polysaccharide capsule is an important virulence factor.
Culture and identification
These organisms have stringent growth requirements; they demonstrate slow growth on blood agar and appear as grey to opaque, translucent colonies. They grow well in Robertson’s cooked meat medium supplemented with yeast extract.
Identified by biochemical tests, growth inhibition by bile salts, antibiotic resistance tests and gas–liquid chromatographic analysis of fatty acid end products of glucose metabolism.
Pathogenicity
Mainly the result of its endotoxin and proteases. No exotoxin has been reported. Other organisms, such as coliforms, are commonly associated with sepsis. The latter facultative anaerobes utilize oxygen in the infective focus and facilitate the growth of the anaerobic Bacteroides strains. Consequently, many Bacteroides infections are polymicrobial in nature.
Treatment and prevention
Sensitive to metronidazole and clindamycin. Resistant to penicillins, first-generation cephalosporins and aminoglycosides. Penicillin resistance is due to β-lactamase production. As Bacteroides spp. are normal gut commensals, infections are endogenous and diseases are virtually impossible to prevent.
Tannerella
Tannerella forsythia (formerly Bacteroides forsythus and Tannerella forsythensis)
Habitat and transmission
Both supragingival and subgingival sites but more common in the latter; the degree of isolation strongly related to increasing pocket depth and, increasingly, recovered from sites that converted from periodontal health to disease and sites with periodontal breakdown, hence considered a consensus periodontal pathogen. Indeed, T. forsythia, Treponema denticola and P. gingivalis are considered the three agents of ‘red complex’ bacteria almost always associated with periodontal disease (see Chapter 33).
Culture and identification
Grows anaerobically, but sometimes requires up to 14 days for visible growth. Growth enhanced by co-cultivation with Fusobacterium nucleatum. Media supplemented with N-acetylmuramic acid enhances growth.
Pathogenicity
Periodontal pathogen in both human and animals; induces apoptotic cell death; invades epithelial cells in vitro and in vivo. Its endotoxin, fatty acid and methylglyoxal production are considered virulence factors; increased levels found in ligature-induced periodontitis and peri-implantitis in dogs.
Porphyromonas
Porphyromonas gingivalis
Habitat and transmission
Found almost solely at subgingival sites, particularly in advanced periodontal disease: considered a consensus periodontal pathogen. As mentioned above, P. gingivalis, T. forsythia and Treponema denticola are considered the three agents of ‘red complex’ bacteria almost always associated with periodontal disease (see Chapter 33). P. gingivalis is sometimes recovered from the tongue and tonsils.
Culture and identification
Grows anaerobically, with dark pigmentation, on media containing lysed blood (Fig. 17.1); identified by biochemical characteristics using commercially available kits (e.g. AnIdent); DNA and molecular probes are now used to identify these organisms directly from plaque samples.
Pathogenicity
An aggressive periodontal pathogen in both humans and animals (e.g. guinea pig, monkey, beagle dogs); its fimbriae mediate adhesion and the capsule defends against phagocytosis. Produces a range of virulence factors including collagenase, endotoxin, fibrinolysin, phospholipase A, many proteases that destroy immunoglobulins, gingipain, a fibroblast-inhibitory factor, complement and haem-sequestering proteins, and a haemolysin.
Prevotella
This genus includes a number of pigmented as well as non-pigmented species that are moderately saccharolytic; all produce acetic and succinic acid from glucose. Prevotella melaninogenica is the type species (Table 17.1).
Prevotella spp.
Habitat and transmission
The predominant ecological niche of all Prevotella species appears to be the human oral cavity. Strains of Prevotella intermedia are associated more with periodontal disease, while Prevotella nigrescens is isolated more often from healthy gingival sites.
Culture and identification
Non-motile, short, round-ended, Gram-negative rods; brown-black colonies on blood agar (when pigmented). Molecular techniques are required to differentiate some species.
Pathogenicity
P. intermedia is closely associated with periodontal disease and shares a number of virulence properties exhibited by P. gingivalis. These organisms are classified as belonging to the ‘orange complex’ bacteria associated with the developmental stages of periodontal disease, and precedes the arrival of the ‘red complex’ group of bacteria (see Chapter 33). The pathogenicity of other subdivided species awaits clarification. Oral non-pigmented species such as Prevotella buccae, Prevotella oralis and Prevotella dentalis are isolated on occasion from healthy subgingival plaque. Some of the latter are associated with disease, and increase in numbers and proportions during periodontal disease.
Key facts
Greenwood D., Slack R., Peutherer J., editors. Medical microbiology, 16th ed., Edinburgh: Churchill Livingstone, 2003. Chs 15–17
Holt S.C., Ebersole J.L. Porphyromonas gingivalis, Treponema denticola and Tannerella forsythia: The ‘red complex’, a prototype polybacterial pathogenic consortium in periodontitis. Periodontology 2000. 2005;38:72-122.
Shah H.N., Mayrand D., Genco R.J., editors. Biology of the species Porphyromonas gingivalis. Boca Raton: CRC Press, 1993.
Tanner A.C.R., Izard J. Tannerella forsythia, a periodontal pathogen entering the genomic era. Periodontology 2000. 2006;42:88-103.
Review questions (answers on p. 353)
Please indicate which answers are true, and which are false.